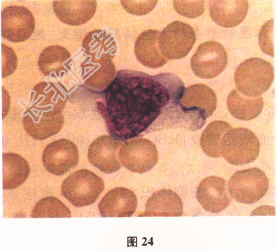

试题详情
- [材料题] 患者女性,26岁,学生。反复发热1个月,伴畏寒,乏力,皮肤瘙痒。咽部充血、疼痛。查体:全身浅表淋巴结肿大,蚕豆大小,无压痛,肝肋下3.5cm,脾肋下3cm。患者曾自行服药,但效果不明显。多次血象检查WBC(15.5~20.5)×109/L。
- 多项选择题1.镜检如图24,某细胞体积较大,外形不规则,胞质丰富,淡蓝色,有透明感,着色不均匀,边缘处蓝色较深呈裙边样。此为
A、单核细胞
B、中性分叶细胞
C、中性杆状细胞
D、嗜酸性粒细胞
E、嗜碱性粒细胞
F、异型淋巴细胞
关注下方微信公众号,搜题查看答案

- 多项选择题2.镜检结果显示,异型淋巴细胞占15%, 最可能的病因是
A、结核病
B、药物反应
C、流行性感冒
D、反应性淋巴细胞增多
E、慢性淋巴细胞白血病
F、传染性单核细胞增多症
关注下方微信公众号,搜题查看答案

- 多项选择题3.下列哪几项不是异型淋巴细胞的形态特点
A、胞体增大
B、胞质样多
C、嗜碱性增强
D、胞质含棒状小体
E、细胞核母细胞化
F、胞质充满细小紫红色颗粒
关注下方微信公众号,搜题查看答案

热门试题
- 符合缺铁性贫血的是A、铁蛋白<12
- 纤溶酶原激活物包括A、Ⅻa、K、HMWK
- 导致直接抗球蛋白试验假阳性的原因包括A、
- 以下疾病会引起红细胞沉降率加快的是A、真
- 发生血友病时的检验结果:A、出血时间延长
- 常用抗凝剂的抗凝原理,错误的是A、氟化钠
- 下列可作为判定急性血管内溶血的证据的是A
- 一个肝素增多症患者,其检验结果可出现下列
- 合格的HiCN转化液必须具备的指标是A、
- 再生障碍性贫血的发病机制是A、成熟细胞结
- 嗜碱性点彩红细胞检测常用的染色方法为A、
- 核酸探针可以是A、人工合成寡核苷酸片段B
- 1、导致以上检测结果的可能原因有A、先天
- 下列哪几项是血小板活化的分子标志物A、β
- 关于染色质小体的叙述,正确的说法是A、直
- APTT和PT均正常的情况见于A、遗传性
- 组织因子途径抑制物(TFPI)抑制的凝血
- 血小板黏附功能与下列哪一项有关( )。
- 下列哪种凝血因子贮存稳定性较差A、Ⅰ、Ⅱ
- 自动血沉仪的主要优点是A、结果与传统魏氏